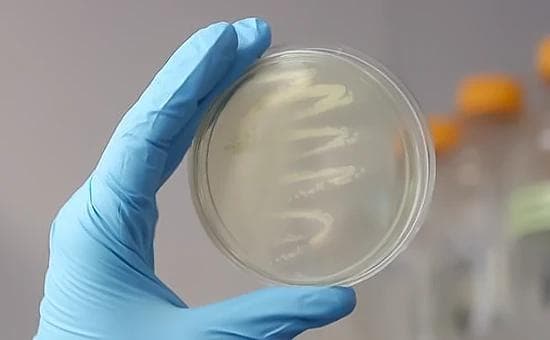

Cleaning with Conscience
Our commitment to sustainability is at the heart of every product. When you clean your home with Bioda’s probiotic-powered products, take pride in exceptional results without toxins and pollutants.

It's not magic—it's microbial! Bioda® products harness the natural power of enzyme-producing probiotics that work tirelessly for a fresher, cleaner home, so homeowners don't have to.
Drain & Septic | Multi-Purpose | Pet Stain & Odor | Pond Care

Our commitment to sustainability is at the heart of every product. When you clean your home with Bioda’s probiotic-powered products, take pride in exceptional results without toxins and pollutants.

Bioda products contain targeted bacterial strains to clean specific soils and odors naturally at the source. We’ve scientifically proven that our probiotics continue to work long after application, up to 21 days.
Our team of expert biologists leverage specialized strains and proprietary nutrient packages to design our cleaning solutions. This science-based approach provides powerful results fast indoors and outdoors.
Your favorite Bioda products are just a click away! Shop our full line of products for a cleaner and greener home exclusively on Amazon. Visit our store and get fast, reliable shipping directly to your door.
Visit Our Amazon Store